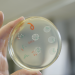

Salz entzieht klein geschnittenem Gemüse das Wasser - in dieser natürlichen Lake kann der Fermentationsprozess beginnen.
Bildauswahl:

Salz entzieht klein geschnittenem Gemüse das Wasser - in dieser natürlichen Lake kann der Fermentationsprozess beginnen.
Was passiert mikrobiologisch bei der Fermentation von Gemüse? Dieser Frage gehen Wissenschaftler an der FH Münster nach.

Sind probiotische Joghurtdrinks sinnvoll? Im Labor der FH Münster untersuchen Mikrobiologen im Auftrag von NANO Doku, wie viele der angepriesenen gesunden Bakterien tatsächlich drin sind.

Fermentieren ist viel mehr als nur Sauerkraut: Beinahe alle Gemüsesorten können zuhause so mit einfachen Mitteln lange haltbar gemacht werden.

Wenn Zucker im Kohl zu Milchsäure umgewandelt wird, entsteht Sauerkraut durch natürliche Fermentation. Der sinkende PH-Wert sorgt dafür, dass ungesunde Mikroorganismen wie Schimmel absterben.

Moderatorin Liyang Zhao beschäftigt sich damit, welche Lebensmittel gesund für den Darm sind.
Themen
Details
Alte Technik - neue Wirkung: Fermentierte Lebensmittel sind mehr als ein Trend. Sie fördern die Gesundheit, stärken das Immunsystem und bringen das Mikrobiom ins Gleichgewicht.
Ob Kimchi, Joghurt oder Käse aus Pilzen - Fermentation ist vielseitig. Sie veredelt den Geschmack und funktioniert traditionell mit Salz oder hoch präzise im Labor. Stanford-Forscher bestätigen: Fermentierte Lebensmittel verbessern nachweislich die Darmflora.
Auf einem Biohof in Mecklenburg-Vorpommern zeigt Olaf Schnelle in einem Workshop, wie einfach „wilde Fermentation“ mit Gemüse funktioniert - nur mit Salz, ganz ohne Zusatzstoffe. Gleichzeitig gibt der Film Einblicke in die Spitzenküche des weltberühmten „Noma“-Restaurants in Kopenhagen, wo Fermente zur Geschmacksinnovation werden.
In Berlin entstehen aus Koji-Pilzen vegane Käsesorten - ganz ohne Tier. Und in Münchner Laboren forschen Wissenschaftler an Präzisionsfermentation mit gentechnisch veränderten Mikroorganismen, um Milchproteine rein synthetisch herzustellen.
Aktuelle Studien der Stanford University belegen die gesundheitsfördernde Wirkung fermentierter Lebensmittel. Schon sechs Portionen am Tag steigern die Vielfalt des Mikrobioms messbar und senken nachweislich Entzündungswerte im Blut.
Die Dokumentation zeigt: Ob Käseersatz oder selbst gemachtes Kimchi - Fermentation ist nachhaltig, gesund und eröffnet kulinarisch wie wissenschaftlich ganz neue Perspektiven.
Um 20.15 Uhr beleuchtet die NANO Doku relevante wissenschaftliche Themen, die uns bewegen. Um 21.00 Uhr diskutieren die Moderatorinnen Alena Buyx und Stephanie Rohde im Wechsel im NANO Talk mit ihren Gästen aus unterschiedlichen wissenschaftlichen Perspektiven über das Thema.
Hinweis
Personen
Top-Spielfilm am 13.11.
Spielfilm
James Bond und sein Partner Alec - Agent 006 - zerstören zur Zeit des Kalten Krieges eine russische Chemiewaffenfabrik, wobei Alec getötet wird. Neun Jahre später in Monaco verfolgt James Bond die schöne Agentin Xenia Onatopp, welche ihn zu der russischen Terrororganisation Janus führt. Diese arbeiten an einem geheimen Waffensystem GoldenEye, welches eine Atombombe im All zündet. Agent 007...
James Bond 007 - Goldeneye